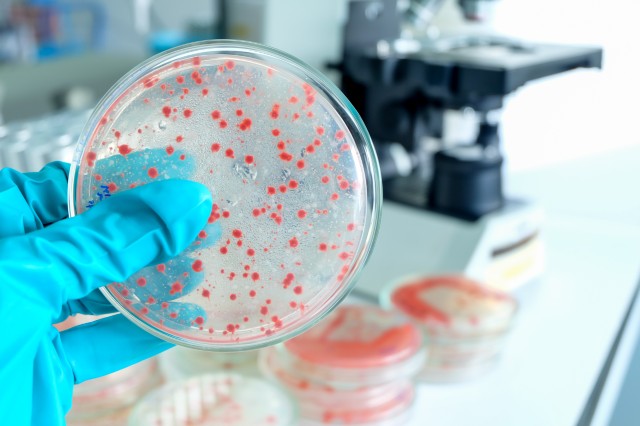
Микробиология и ГМО

Юрофинс Фуд енд Енвайрънмънт Тестинг България
Търсене >>
Юрофинс ХОС Тестинг България
ЛАБОРАТОРНИ ИЗПИТВАНИЯ
За нас
Юрофинс Фуд енд Енвайрънмънт Тестинг България е ангажиран поддръжник на развитието на безопасността и качеството на храните в България, поради което предоставя възможно най - широкото портфолио от лабораторни тестове за храни и фуражи. С помощта на лабораториите в групата на Eurofins гарантираме високото ниво на микробиологичните и аналитичните тестове, изисквани от нашите партньори.
Лабораторията ни в България се намира в гр. София и извършва анализ на храни, фуражи и води, като сме сертифицирани по ISO/IEC 17025:2017 и притежаваме сертификат от ANAB за определен обхват и работа на лабораторията.